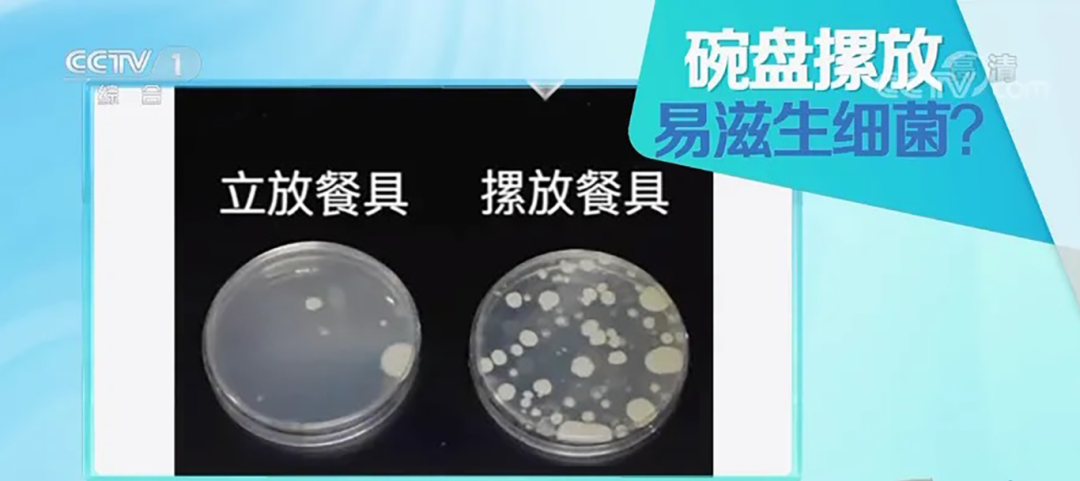

洗碗是
很多人几乎每天都会做的事
但这一看似简单的日常行为
其实很容易因不良习惯
成为癌症高发的“帮凶”
近日,有媒体发文
进行提醒

那么,不正确的洗碗方式
都潜藏着哪些
令人意想不到的健康隐患呢?
赶紧“避雷”
↓↓↓
五个常见的洗碗坏习惯
习惯一:清洁工具不勤更换
很多家庭常年使用同一块洗碗布或钢丝球,但这些清洁工具的内部纤维容易积聚食物残渣,成为细菌滋生的温床。比如沙门氏菌、大肠杆菌等病菌会在清洁工具表面繁殖,增加肠胃炎和癌症的风险。

习惯二:用过的餐具堆积不洗
很多人习惯将用过的碗筷堆积在水槽,但研究表明,堆积餐具上的油脂和残渣甚至可能导致霉菌毒素产生,如黄曲霉毒素,这是一种强致癌物质。
特别是夏天,餐具上的残留物在高温环境中迅速发酵,成为细菌和霉菌的滋生地。
习惯三:滥用洗洁精
很多人认为多用洗洁精可以提高清洁效果,但其实若未彻底冲洗,洗洁精中的化学成分可能残留在餐具表面,长时间摄入可能对肝脏造成损害,并增加癌症风险。
习惯四:碗底清洁不仔细
很多人洗碗时只关注碗内表面的清洁,而忽略碗底和边缘,这些地方容易积聚残留物。堆放时,未清洁的碗底会将污垢转移到下一个碗,造成交叉污染。
此外,这些残留物在潮湿环境中为细菌提供了理想的繁殖条件。
习惯五:湿碗筷直接收进橱柜
很多人在洗完碗筷后,未晾干直接收进橱柜,湿润的环境为霉菌生长提供了温床,特别是木质筷子在潮湿条件下容易发霉,甚至产生黄曲霉毒素,对人体健康造成威胁。
另外,还有很多人洗完碗碟后,喜欢将碗碟叠放在一起。然而,这种做法却容易导致碗碟内部残留水分和细菌。
据“科普中国”报道,此前,中国家用电器研究院做了一组试验,该试验设置了两组对比。试验员首先给餐具进行了消毒,在餐具表面涂上了无菌肉汤,之后将餐具分为两组,其中一组碗盘清洗后直接摞起来放到了碗柜中储存,另一组洗后立着放于置物架上,并放于通风处。
三天后对比显示,立着餐具的菌落总数为8000cfu/套,符合我国相关卫生标准;而摞着放的细菌数量是560000cfu/套,为立着放的70倍。
上述习惯
看似无伤大雅
但却暗含健康隐患
不可忽视!
如何正确洗碗?
赶紧码住以下小贴士
正确洗碗“姿势”
1. 及时清洗不浸泡
吃完饭后,应立即将碗碟放入水池中清洗,避免长时间浸泡。使用流动的温水和适量的洗洁精,用软海绵或洗碗布轻轻擦拭碗碟表面,确保清洗干净。
2. 选择正规洗洁精
购买洗洁精时,应选择正规品牌、质量可靠的产品。避免购买劣质洗洁精,以免对家人健康造成危害。同时,也要注意洗洁精的用量,不要过多使用,以免浪费和残留。
3. 经常清洗洗碗布
每天清洗洗碗布,并定期更换新的洗碗布。清洗时,应使用流动的温水和适量的洗洁精,将洗碗布彻底清洗干净。同时,也要避免将洗碗布与油腻、污浊的物品放在一起,以免滋生细菌和霉菌。
4. 使用流动水冲洗
洗碗时,应使用流动水冲洗碗碟。流动水可以有效冲走碗碟上的污垢和细菌,确保碗碟清洗干净。同时,也要注意控制水温,避免使用过热或过冷的水,以免对碗碟和手部造成伤害。
5. 晾干碗碟再存放
洗完碗碟后,应将碗碟分开晾干或使用干净的布擦干。避免将碗碟叠放在一起,以免内部残留水分和细菌。同时,也要定期清洗和消毒橱柜等存放碗碟的地方,确保环境清洁卫生。
朋友们,赶紧自查!
你平时洗碗是否也有
容易被忽略的坏习惯?
从今天起
洗碗请调整一下!
保障你的健康安全哦~
信息来源 | 澎湃新闻、科普中国、信阳美好生活